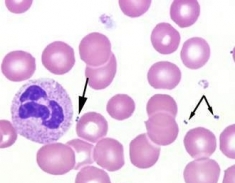
bacteria-in-stained-sample
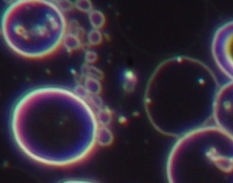
bacteria-and-symprotits-in-dark-field
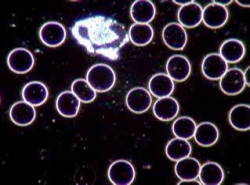
mainly-symprotits
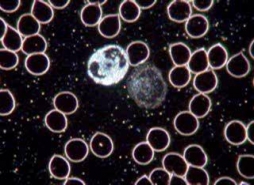
mainly-chylomicrons

Enderlein’s Endobiont and Prusiner’s Prion
Prof. Enderlein observed blood samples with the technique of dark field microscopy, which is also called live blood analysis. As the name suggests, the blood cells and particles are alive and not dead like in stained samples used by hematologists
Bacteria for instance, can be seen in stained samples as dead objects and in dark field alive and kicking. Symprotits are small particles, which can not be seen in bright field. Prof. Enderlein observed these particles, which can clearly be seen in live blood samples in dark field, changing and developing into other forms. His problem was to name these particles and forms observed. There was no description of it in any valid medical literature at the time. So he started to name them himself and created a terminology, mainly deriving from Greek words that never found their way into hematological textbooks.
The very basic particle, ground form of all other developments, he called “Endobiont”, deriving from the Greek word endobios (endo = inside, bios = live). The word endobios is clearly defined by Thesaurus as “live of organisms within a medium or an organ of animals and human beings, e.g. in the intestines”. These relationships can be symbiotic (endosymbiosis) or damaging (endoparasitism).
Enderlein’s definition of the “Endobiont”: Proteinaceous particle of plant origin, found in all mammals, including human beings. This particle has intra and extra cellular regulatory effects. Unhealthy changes of the environment (biological terrain) can lead to pathological developments of the endobiont bringing about disease. His conclusion that this proteinaceous particle is of plant origin stems from his experiment of culturing erythrocytes with these particles in it that developed into a strain of mucor racemosus.
![]() |
![]() |
|---|---|
| Bacteria in stained sample | Bacteria and Symprotits in dark field |
A protein, as per definition, is a chain of about 200 amino acids, which is molecule size and impossible to see with a dark field microscope or even with an electron scanning microscope. Only conglomerates of millions of these proteinaceous particles can be seen in dark field. Prof. Enderlein called them “Protits”, “Symprotits” and “Macrosymprotits”. Their erratic movements observed in dark field is due to Brownian motions, which is a term used in Physics to describe the bouncing of molecules of each other. “Protits”, “Symprotits” and “Macrosymprotits” are often mistaken for chylomicrons (tiny fat droplets from food uptake) by dark field microscopists. It is therefore best to take a fasting blood sample for dark field microscopy.
![]() |
![]() |
|---|---|
| Mainly Symprotits | Mainly Chylomicrons |
Enderlein’s “Endobiont” only had meanings to dark field microscopists following his teaching and was frowned upon by conventional medical science.
All of this changed by the outbreak of “mad cow’s disease” in 1996. People reportedly became infected by contaminated beef suffering “Creutzfeld-Jacobs-Disease”, the equivalent in humans. This lead to the slaughter and burning of all cattle stock in the UK. No conventional scientist could identify a virus, bacteria, fungus or parasite causing this disease. Under enormous pressure to calm people and come up with an answer, established scientists finally recognized Prof. Prusiner’s work of many decades and his discovery of the “Prion” as an infection causing entity. In 1997 he was awarded the Nobel Prize in Physiology and Medicine. In his acceptance speech at the Karolinski Institute in Sweden he said: “There are hints that the prions causing the diseases explored thus far may not be the only ones”.
So, what has this all got to do with Enderlein’s “Endobiont”?
To answer this question look at Prof. Prusiner’s definition of a “Prion”: “Small proteinaceous infectious particle, which resists inactivation by procedures that modify nucleic acids.” Unlike known infectious agents, prions contain no genetic material and are simply proteins. Furthermore, the gene encoding for prions is found in all mammals, including humans. Prusiner’s work found that, under normal conditions, prions are innocuous, but they have an innate ability to convert into harmful structures.
You do not have to be Einstein to figure out that Prusiner’s “Prion” and Enderlein’s “Endobiont” describe the same proteinaceous particle. If it wasn’t for the scare of “mad cow’s disease” and infection of humans by it, conventional scientists would still laugh at Prusiner’s discovery of “Prions” as they have done for decades earlier. The Nobel citation from Sweden’s Karolinska Institute said: “Prusiner has added prions to the list of well-known infectious agents, including bacteria, viruses, fungi and parasites”. If the outbreak of “mad cow’s disease” would have happened 60 years earlier, Enderlein’s “Endobiont” might have been the recognized terminology for it.
Enderlein identified what he called “unhealthy changes of the environment” as culprit of pathological developments of the endobiont. We now know these changes are mainly due to disturbance of the acid-base balance in extra cellular fluids. A “rotten apple effect” is also blamed, which means, one structurally changed disease forming proteinaceous particle can infect others.
Enderlein’s research found that adding normal stage protits to pathologically developed stages helped to reduce these forms back to benign ones. He created what he called “isopathic remedies”, which he made from endobiontic forms (=Prions) of different strains of fungi.
SEE ALSO: Live Blood Microscopy Analysis Darkfield Course: Detailed Outline
Latest research by Prusiner’s institute and other researchers around the world indicates Diabetes Type II, Parkinson’s disease, Alzheimer’s disease and Motor Neuron disease to be prion related diseases (1, 2). Enderlein’s “isopathic remedies” could therefore be the ideal medication to treat those diseases. Problem is, there is no guarantee that these remedies do not contain rogue prions or endobionts that have this “rotten apple effect” and accelerate the disease in the first place.
Related Sites
References:
- Stanley B. Prusiner – Prion Biology and Diseases
- http://www.sciencedaily.com/releases/2007/04/070430102021.htm